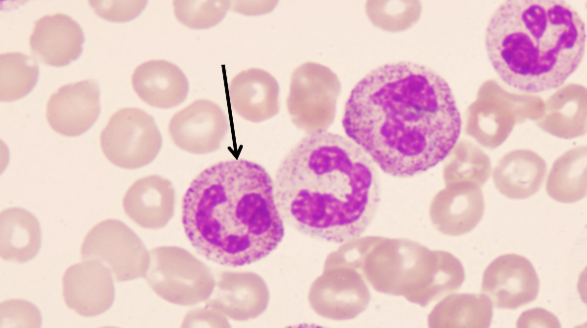
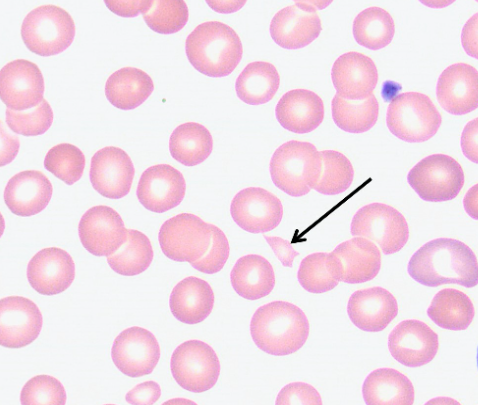

【第一百三十九期】基层检验网形态学培训
【第一百三十九期】基层检验网形态学培训
每周一次,每次几张,只要您坚持来,抽出几分钟的时间,相信您的识图能力会不知不觉的提升哦
1、箭头所指细胞名称 骨髓标本 10×100倍:

答案:中幼红细胞
解析:又叫嗜多色性红细胞。系骨髓中的一种过渡形态的红细胞。此细胞体积比早幼红细胞体积小,直径为10~14μm左右。胞核随胞体变小,核染色质粗糙呈团块样,着色较深,核仁已消失。
2、 箭头所指细胞名称 骨髓标本 10×100倍:

答案:异型淋巴浆细胞
解析:异性淋巴细胞又称为反应性淋巴细胞,是指在病毒、寄生虫、感染、药物反应、应激状态或过敏原等刺激因素的作用下,因细胞增生,出现胞体增大、胞质增多、嗜碱性增强、细胞核母细胞化等表现的淋巴细胞。异型淋巴细胞按照形态主要分为三类,Ⅰ型又称为泡沫型或浆细胞型,Ⅱ型又称为单核细胞型,Ⅲ型又称为未成熟型或幼稚型。
3、请报告箭头所指细胞名 外周血涂片 瑞氏-吉姆萨染色:
答案:含中毒颗粒的中性粒细胞
解析:中毒颗粒为中性粒细胞胞质中出现的较粗大 、 大小不等 、 分布不均的深蓝色或蓝黑色颗粒。在较严重的化脓性感染、大面积烧伤及恶性肿瘤时多见。这些颗粒被称为“中毒颗粒”。出现中毒颗粒时表明有化脓性感染。
4、请报告箭头所指细胞名 外周血涂片 瑞氏-吉姆萨染色:
答案:裂片红细胞
解析:红细胞碎片或不完整的红细胞,大小不一,外形不规则,系红细胞通过因阻塞而管腔狭小的微血管所致 。正常人血涂片中裂片红细胞小于2% 。弥散性血管内凝血、微血管病性溶血性贫血时增多
5、请报告箭头所指细胞名:


答案:柴捆细胞
解析:胞体大,内质外浆明显; 胞质中含有大小不一,密集的紫红色非特异性颗粒,可见多根Auer小体,呈“柴捆”样排列;细胞核折叠扭曲,呈“香梨形”或“蝴蝶形”核,核染色质粗细不等,核仁隐约可见。
感谢:重医大附一院检验科和其管辖医院提供的内容。


